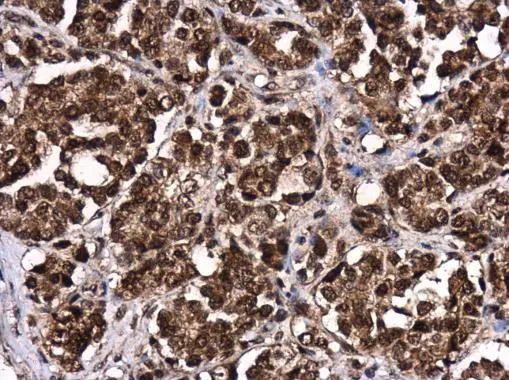
LIN28B antibody detects LIN28B protein at cytoplasm and nucleus in human colon by immunohistochemical analysis. Sample: Paraffin-embedded human colon. LIN28B antibody (GTX131546) diluted at 1:500. 
 Antigen Retrieval: Citrate buffer, pH 6.0, 15 min

Whole cell extract (30 μg) was separated by 10% SDS-PAGE, and the membrane was blotted with LIN28B antibody (GTX131546) diluted at 1:1000.
LIN28B antibody
GTX131546
ApplicationsWestern Blot, ImmunoHistoChemistry, ImmunoHistoChemistry Paraffin
Product group Antibodies
ReactivityHuman
TargetLIN28B
Overview
- SupplierGeneTex
- Product NameLIN28B antibody
- Delivery Days Customer9
- Application Supplier NoteWB: 1:500-1:3000. IHC-P: 1:100-1:1000. *Optimal dilutions/concentrations should be determined by the researcher.Not tested in other applications.
- ApplicationsWestern Blot, ImmunoHistoChemistry, ImmunoHistoChemistry Paraffin
- CertificationResearch Use Only
- ClonalityPolyclonal
- Concentration0.51 mg/ml
- ConjugateUnconjugated
- Gene ID389421
- Target nameLIN28B
- Target descriptionlin-28 RNA binding posttranscriptional regulator B
- Target synonymsCSDD2, protein lin-28 homolog B, Lin-28.2, lin-28 homolog B, lin-28B
- HostRabbit
- IsotypeIgG
- Protein IDQ6ZN17
- Protein NameProtein lin-28 homolog B
- Scientific DescriptionActs as a suppressor of microRNA (miRNA) biogenesis by specifically binding the precursor let-7 (pre-let-7), a miRNA precursor. Acts by binding pre-let-7 and recruiting ZCCHC11/TUT4 uridylyltransferase, leading to the terminal uridylation of pre-let-7. Uridylated pre-let-7 miRNAs fail to be processed by Dicer and undergo degradation. Specifically recognizes the 5-GGAG-3 motif in the terminal loop of pre-let-7. Also recognizes and binds non pre-let-7 pre-miRNAs that contain the 5-GGAG-3 motif in the terminal loop, leading to their terminal uridylation and subsequent degradation. Mediates MYC-mediated let-7 repression. Isoform 1, when overexpressed, stimulates growth of the breast adenocarcinoma cell line MCF-7. Isoform 2 has no effect on cell growth.
- ReactivityHuman
- Storage Instruction-20°C or -80°C,2°C to 8°C
- UNSPSC12352203